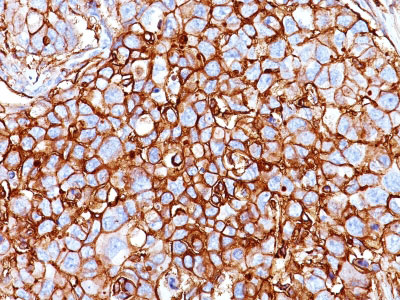

> Antigen, Antibodies, ELISA, Western Blot > Primary Antibody > Monoclonal Antibodies > CD44 / HCAM Std. Antibody - Without BSA and AzideBrand |
Leading Biology | Catalog Number |
AMM01577G |
Product Type |
Monoclonal Antibodies | Field of Research |
|
Product Overview |
We constantly strive to ensure we provide our customers with the best antibodies. As a result of this work we offer this antibody in purified format.
We are in the process of updating our datasheets. If you have any questions regarding this update, please feel free to contact our technical support team.
This product is a high quality CD44 / HCAM Std. Antibody - Without BSA and Azide.
|
||
Molecular Weight |
80-95kDa
|
||
Cellular Localization |
Antigen Cellular Localization:
Cell membrane; Single-pass type I membrane protein. Note=Colocalizes with actin in membrane protrusions at wounding edges.
|
||
Host |
Mouse
|
||
Species Reactivity |
Human
|
||
Clone |
HCAM/918
|
||
Isotype |
Mouse / IgG2a, kappa
|
||
Symbol |
LHR, MDU2, MDU3, MIC4
|
||
GeneID |
|||
UniProt ID |
|||
Function |
Receptor for hyaluronic acid (HA). Mediates cell-cell and cell-matrix interactions through its affinity for HA, and possibly also through its affinity for other ligands such as osteopontin, collagens, and matrix metalloproteinases (MMPs). Adhesion with HA plays an important role in cell migration, tumor growth and progression. In cancer cells, may play an important role in invadopodia formation. Also involved in lymphocyte activation, recirculation and homing, and in hematopoiesis. Altered expression or dysfunction causes numerous pathogenic phenotypes. Great protein heterogeneity due to numerous alternative splicing and post-translational modification events.
|
||
Summary |
Recognizes a cell surface glycoprotein of 80-95kDa (CD44) on lymphocytes, monocytes, and granulocytes (Leucocyte Typing Workshop V). Its epitope is resistant to digestion by trypsin and chymotrypsin. The CD44 family of glycoproteins exists in a number of variant isoforms, the most common being the standard 85-95kDa or hematopoietic variant (CD44s). Higher molecular weight isoforms are described in epithelial cells (CD44v), which are believed to function in intercellular adhesion and stromal binding. CD44 immunostaining is commonly used for the discrimination of urothelial transitional cell carcinoma in-situ from non-neoplastic changes in the urothelium.
|
||
Form |
Liquid |
||
Storage & Stability |
Store at +4°C short term. For long-term storage, aliquot and store at -20°C or below. Stable for 12 months at -20°C. Avoid repeated freeze-thaw cycles.
|
||
Applications |
IHC, IF, FC
|
||
Images |
Formalin-fixed, paraffin-embedded human Breast Carcinoma stained with CD44 Monoclonal Antibody (HCAM/918) 
Western Blot of DU145 Cell Lysate using CD44 Monoclonal Antibody (HCAM/918). |
||
Specification |
|||
Quantity |
|
||
| Select | Brand | Catalog No. | Product Name | Pack Size | Type | Field of Research | Specification | Quantity | Price(USD) | |
| 1 | Leading Biology | APG02467G | CCK4 / PTK7 Antibody (clone 4F9) | 50 μl | Monoclonal Antibodies |
|
$495.00 | Add Ask | ||
| 2 | Leading Biology | AMM04683G | GALT Antibody (clone 4C11) | 50 μg | Monoclonal Antibodies |
|
$545.00 | Add Ask | ||
| 3 | Leading Biology | AMM01402G | Vimentin (Mesenchymal Cell Marker) Antibody - With BSA and Azide | 50 ug | Monoclonal Antibodies |
|
$395.00 | Add Ask | ||
| 4 | Leading Biology | APR08280G | LTA4H / LTA4 Antibody (clone 9G8) | 50 μl | Monoclonal Antibodies |
|
$495.00 | Add Ask | ||
| 5 | Leading Biology | AMM00172G | CD1a / HTA1 (Mature Langerhans Cells Marker) Antibody - With BSA and Azide | 50 ug | Monoclonal Antibodies |
|
$395.00 | Add Ask | ||
| 6 | Leading Biology | AMM05750G | CEBPA Antibody | 100 μl | Monoclonal Antibodies |
|
$545.00 | Add Ask |
 Leading Biology Inc.
2600 Hilltop DR, Building G, B Suite C138
Richmond, CA, 94806
Tel: 1-661-524(LBI)-0262
Email: info@leadingbiology.com
Leading Biology Inc.
2600 Hilltop DR, Building G, B Suite C138
Richmond, CA, 94806
Tel: 1-661-524(LBI)-0262
Email: info@leadingbiology.com
Complete this form and click send to ask us a question, request a quote or simply say hello.

You have 0 item in your cart

You have 0 item in your inquiry list
